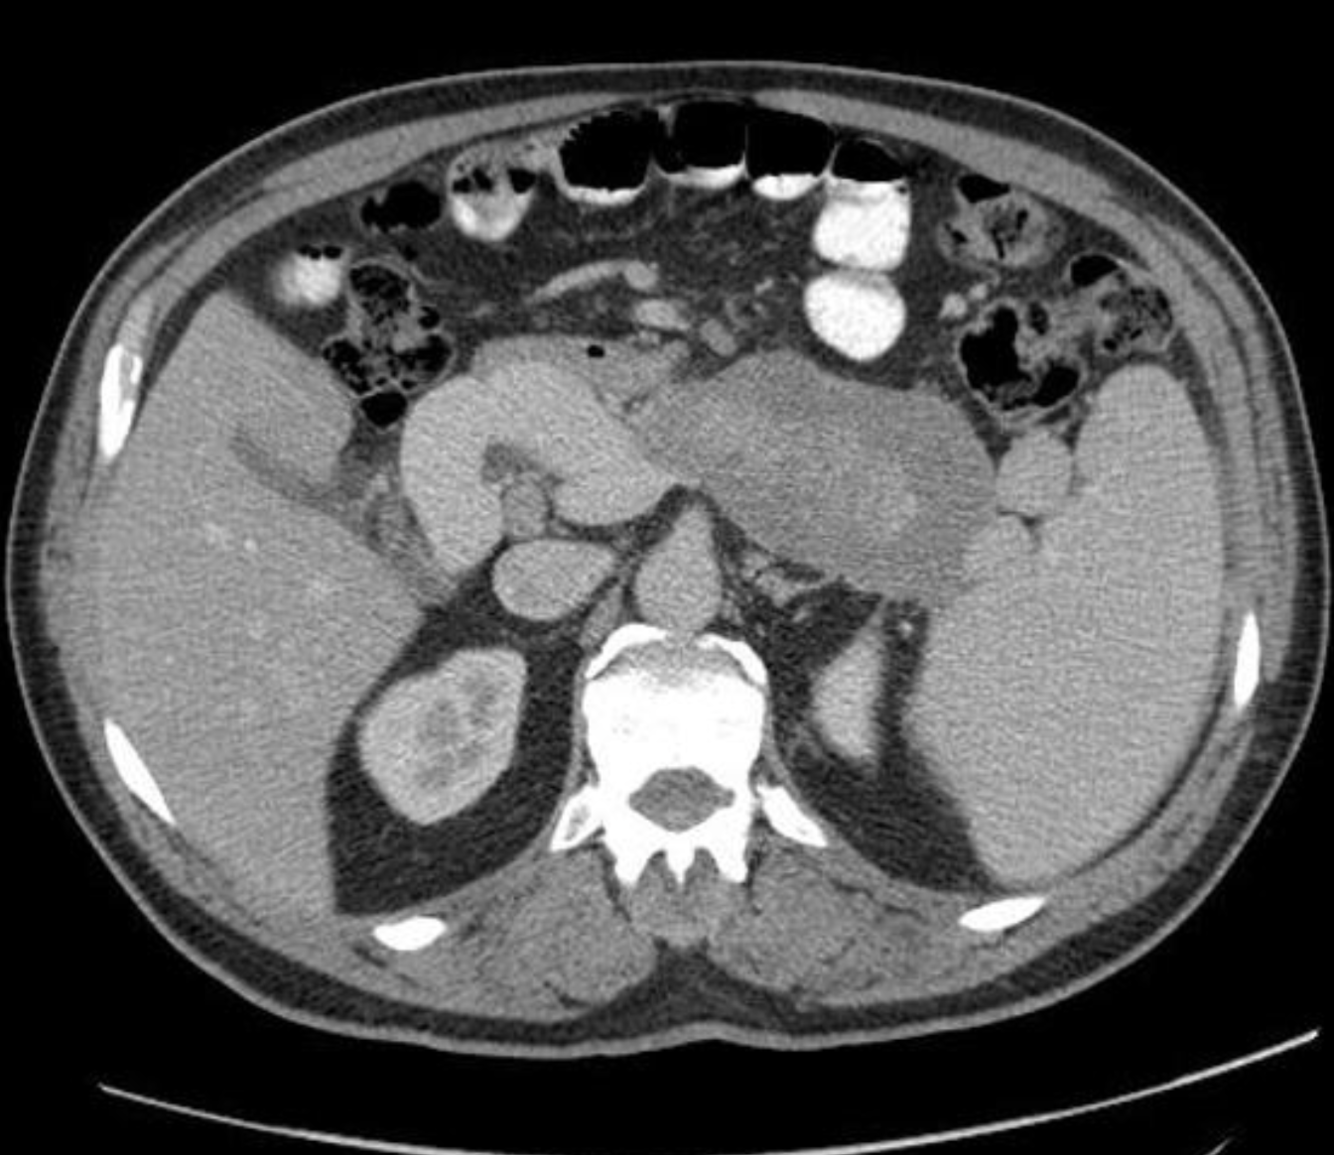
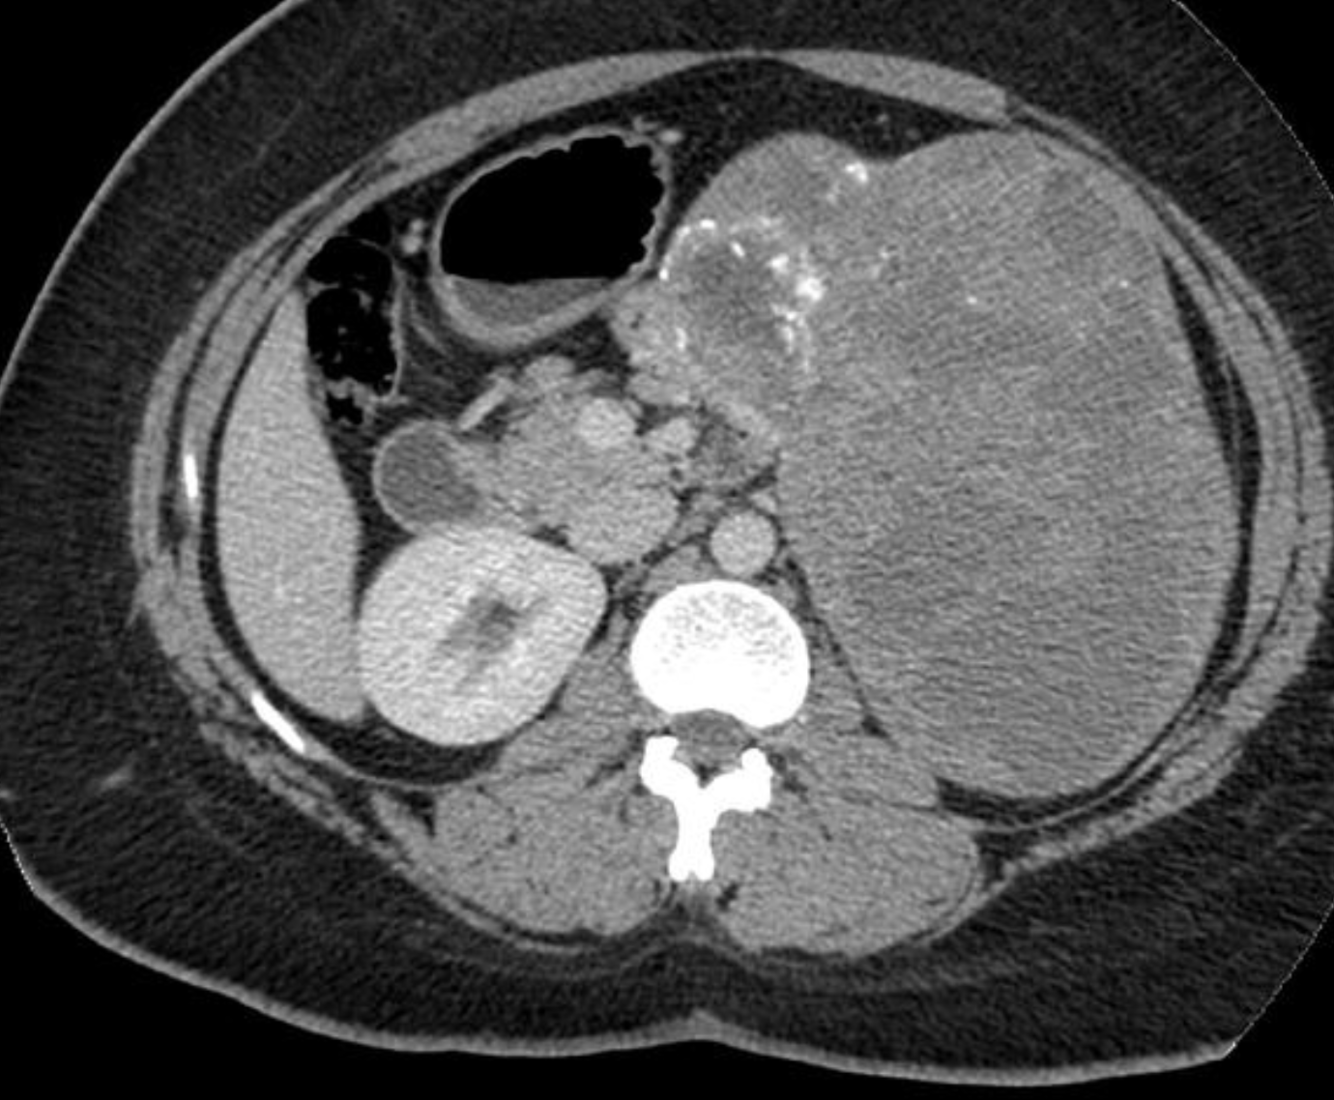

what is this?
age group?
Assocaitions

pancreaticoblastoma
- rare primary pancreatic neoplasm of child hood
- Usually pts between 1-8 yo
- reported in neonates and adults
- A congenital form is A/w Beckwith widemann syndrome
- Slow growing
- uaully large at presentation
- large well defined multilobulated masses with enhancing septa by ct
- mixed echotexture seen on US
- The tumours are soft and gelatenous and if arising in the pancreatic head, do not usually produce obstructive symptoms.

Radiology Findings of Autoimmune Pancreatitis
- US
- Focal hypoechoic diffuse enlargement of gland
- gland may be normal in appearance
- CBD may be dilated
- CT
- diffuse enlargement of the pancreas
- loss of normal surface indentations
- tail retracted from splenic hilum
- capsule-like rim enhancement around gland
- peripancreatic adenopathy
- no calcificaiton
- vascular encasement of CBD dilatation
- Can have typical linea ‘cut off’ from normally enhancing pancreas to more distal hypoenhancing pancreas
Single phase CT scan (multiphase scans not performed due to age of patient) demonstrates a diffusely enlarged pancreas with a “halo” like rim of hypoattenuating tissue which is smoothly marginated. Minimal peripancreatic fat stranding.
Associated splenic vein thrombosis, splenomegaly and cavernous transformation of the portal vein.
what is this tumour?
who does it occur in?
- Solid pseudopapillary neoplasm
- AKA
- Frantz tumour
- solid and cystic acinar tumour
- Papillary epithelial neoplasm
- solid and papillary epithelial neoplasm
- DAUGHTER TUMOUR
- Large lesions of epithelial tissue that are slightly more common in body/tail
- well-demarcated mixed solid and cystic hemorrhagic mass
- solid components with enhacment
- may contain calcificaitons
- good prognosis after resection
- women <50yo
- Solid pseudopapillary tumours of the pancreas are rare (usually benign) pancreatic tumours.
Terminology
The tumour has been referred to with multiple different names, including:
solid pseudopapillary tumour (SPT) of the pancreas
solid pseudopapillary neoplasm (SPN)
solid pseudopapillary epithelial neoplasm (SPEN)
papillary cystic neoplasm of the pancreas
Hamoudi tumour
Gruber-Frantz tumour (or just Frantz tumour)
Epidemiology
They are rare and thought to account for 1-2% of exocrine pancreatic tumours. They tend to present in young non-Caucasian females around the 2nd and 3rd decades of life (the ‘daughter’ tumour) 10.
Associations
pancreatic dorsal agenesis: possible association 5
Clinical presentation
Most patients are asymptomatic at diagnosis. They may occasionally present with a gradually enlarging abdominal mass or vague abdominal pain.
Pathology
The tumours frequently contain varying amounts of necrosis, haemorrhage, and cystic change. Lesions can be large at time of diagnosis (median size ~8 cm) 2.
Location
There is a greater predilection to occur at pancreatic tail.
Imaging features of Chronic Pancreatitis

- Size
- commonly small, uniformly atrophic pancreas
- focal enlargement from normal or inflamed pancreas bay be coexistent 40%
- Tissue
- fatty replacement
- fibrosis
- parenchymal calcificaitons
- intraductal calculi
- Ducts
- Irregular dilation of PD
- Side branches may have clubbed appearance
- MRI study shows dilated beaded main pancreatic duct measures about 7 mm with associated thinned out pancreatic parenchyma, smooth pancreatic surface, and loss of normal lobulation. Dilated side branches of the pancreatic duct giving a “chain of lakes sign”. Multiple filling defects are seen within the proximal main pancreatic duct best seen on DWI and coronal T2 space as low signal intensities suggestive of intraductal calculi
Multiple variable size GB stones are also noted.
- https://radiopaedia.org/cases/chronic-pancreatitis-chain-of-lakes-sign-1

Intraductal Papillary Mucinous Neoplasms of the pancreas
Types 2
associations 3
- Types
- side branch
- Main duct lesions
- Associations
- Adenocarcinoma (25%)
- Hyperplasia (25%)
- Dysplasia (50%)

Complications of Chronic Pancreatitis

- Pseudocysts 30%
- Obstructed CBD 1-%
- Venous Thrombosis
- splenic
- portal
- mesenteric veins
- Increased Risk of Cancer
- Malabsorption/steatorrhea 50%
Generalised atrophy of body and tail of the pancreas. Diffuse parenchymal calcification with main pancreatic duct dilated throughout its course with a beaded appearance reaching up to 10mm in diameter. Multiple intraductal calculi are present, the largest measuring 10 mm in the pancreatic head. This stone is obstructing the main pancreatic duct resulting in ductal dilatation. No hypoenhancing pancreatic parenchymal lesions. No peripancreatic fat stranding or localised collections. No radio-opaque stones in the gallbladder, cystic duct, or common bile duct. No intrahepatic biliary duct dilatation.
Case Discussion
When presenting with an episode of abdominal pain, this patient underwent an ultrasound of the abdomen which revealed features of chronic calcific pancreatitis. However, due to the suboptimal acoustic window, a CT scan was recommended to rule out any pancreatic inflammation or neoplasm. The chronic inflammatory changes result in reduction in volume of pancreatic parenchyma with only a ghost of the gland remaining in the latter stages. These patients are more prone for neoplasms and have to be watched closely.
https://radiopaedia.org/cases/chronic-calcific-pancreatitis-with-obstructing-stone
what is this?
Increased risk of what

Tropical Pancreatitis
- Variant of Chronic pancreatitis
- young age at onset
- usually no alcohol abuse
- a/w malnutrition
- regional predisposition in tropical countries
- rapidly progressive course with severe pancreatitis
- presence of large intraductal calculi
- increased risk of adenocarcinoma
What is this sign and condition?

- Colon cut off sign
- The colon cut-off sign describes gaseous distension seen in the proximal colon associated with abrupt termination of gas within the colon usually at the level of the splenic flexure and decompression of the more distal part of the colon. Though originally described in abdominal radiographs, this sign has also been demonstrated on contrast enemas and computed tomography 1.


Replaced right hepatic artery (RHA) arising from the superior mesenteric artery (SMA).
Case Discussion
The right hepatic artery arises from the superior mesenteric artery (SMA), also referred to as “replaced to the SMA”, in 9 to 15% of the population. It is the most common variant in hepatic arterial anatomy.
Core tip: Appreciation and study of hepatic arterial anatomical variability is essential to the successful performance of complex pancreaticobiliary procedures. An aberrant right hepatic artery (aRHA) represents the vascular anomaly encountered most frequently during pancreatoduodenectomy (PD) and, because of its course, is most susceptible to intraoperative damage and tumor involvement. When an aRHA is present, the challenge in peripancreatic malignant disease is to balance its preservation and the need to achieve oncological clearance. In this study, we analyzed the incidence of aRHA and its relationship with the operative complexity, occurrence of complications and oncological clearance in a large cohort of patients undergoing PD.
An aRHA represents the vascular anomaly encountered most frequently during PD. It may have a suprapancreatic, intrapancreatic or rarely transpancreatic course, and, because of its course, it is most susceptible to intraoperative damage and tumor involvement[4,5]. The incidence of an aRHA identified in patients undergoing PD varies from 11%-26.5%[1,6]. When an aRHA is present, the challenge in peripancreatic malignant disease is to balance between its preservation and the need to achieve oncological clearance, which represents the only chance for prolonged survival[1,5,7]. The presence of an aRHA leads not only to an alteration in the surgical approach, but may also adversely affect the outcomes of the surgical procedure[5,8]. In this study, we analyzed the incidence of aRHA and its relationship with the operative complexity, occurrence of complications and oncological clearance in a large cohort of patients undergoing PD.

Where does the duct of Wirsung enter into?
what is the upper size limit of the PD
- The duct of wirsung enters into the major papilla with the CBD
- The duct of santorini empties into the minor papilla
- Both pancreatic ducts communicate with each other near the neck of the pancreas, forming a single remaining duct that runs through the center of the body and tail of the pancreas
- The upper size limit of the main duct in young adults is 3mm, older adults 5mm


- mucinous cystic neoplasm of the pancreas
- MCN
- large peripheral tumours surrounded by thick fibrous capsule.
- the cyst cavity is filled with muycinous material
- Unlike Intraductal papillary mucinous tymours (IPMT) there is no connection to the pancreatic duct
- AKA
- mucinous macrocytic neoplasm
- Mucinous Cystadenoma
- Mucinous Cystadenocarcinoma
- Macrocystic adenoma
Mucinous cystadenomas (MCN) of the pancreas are a type of mucinous cystic neoplasm of the pancreas.
Epidemiology
Previously believed to occur exclusively in middle age females 5, it has occasionally been described in males 6,7.
Pathology
It is a large uni/multilocular cystic pancreatic neoplasm lined by columnar mucinous epithelium. While mucinous cystadenomas very infrequently communicate with the pancreatic duct 13, they can cause partial pancreatic ductal obstruction 11. They are considered premalignant or malignant lesions with usually elevated CEA and CA 19-9 serum levels.
Location
Largely (~80%) occur in the body or tail of the pancreas, and less commonly in the head of the pancreas (~20%) 11.
Radiographic features
CT
the tumour contour tends to be rounded or ovoid although this is not an absolutely specific feature 2
associated calcification when present tends to be more peripheral 1,11
contents of the lesion may be heterogenous in attenuation 2
internal septations may be present and tend to be linear or curvilinear 2
Differential diagnosis
On ultrasound or CT consider:
mucinous cystadenocarcinoma of the pancreas: at times almost impossible to differentiate on ultrasound or CT from a mucinous cystadenoma 8
pancreatic pseudocyst
oligocystic variant of serous cystadenoma of the pancreas
pancreatic hydatid cyst 14
Findings: A well-defined rounded exophytic cystic lesion measuring 6.3 x 7 x 7 cm is seen originating from the tail of the pancreas. It has an average density of 8 HU and shows mild peripheral enhancement on post contrast study. A few thin septations and a tiny mural calcification are seen in it. No solid component is seen in it. Morphology of the remaining pancreas is unremarkable.
Impression: Well-defined rounded exophytic cystic lesion originating from the tail of the pancreas, which is likely, a mucinous cystadenoma of the pancreas (mucinous cystic neoplasm of the pancreas) with possible differential diagnosis of pancreatic pseudocyst (if there is a past history of pancreatitis). Another possible differential can be a hydatid cyst which is however, very unlikely.
https://radiopaedia.org/cases/mucinous-cystadenoma-of-the-pancreas-4

Infected fluid collections
- Any of the following can be infected
- walled off necrosis
- pseudocyst
- acute peripancreatic fluid collections
- air in a fluid collections suggests infection by a gas forming bacterium
- pitfulls of calling infection by presence of air:
- fistulization to bowel
- or previous manipulation
Islet cell Neoplasm
AKA
Which cells do they arise from?
Types?
Classification

Islet cell Neoplasm/AKA neuroendocrine Tumours
- arise from multipotential stem cells.
- pancreatic endocrine tumours have commonly been referred to as “islet cell tumours”, referring to the islets of Langerhans, from which they were thought to derive.
- It has since been shown that these tumours derive from ductal pluripotent stem cells, and “endocrine tumour” is now preferred.
- APUD
- amine
- precursor
- uptake and
- decarboxylation
- systme
- Classification
- functional 85%, secretion of one or more hormones
- Insulinoma (most common functional tumour)
- Gastrinoma (2nd most common)
- Glucagonoma
- VIPoma
- Somatostatinoma
- non functional (3rd most common)
- functional 85%, secretion of one or more hormones
What are the Cystic neoplasms of the pancreas?
- Mucin producing tumours
- Intraductal Papillary Mucinous Neoplasm/tumour (IPMN)
- Mucinous Cystic Neoplasm (MCN)
- Serous Cystadenoma
What is this?

Fatty infiltration of the pancreas
- Common
- normal findings with increasing age.
- Also seen in DM and other endocrine dysfunction
- Fatty distribution is often uniform
- Focal sparing around CBD is common
- Lobulated external contour
diagnosis?
A/w which disease?

- Pancreatic Cystosis
- Pancreatic cystosis (PC) is an uncommon manifestation of pancreas involvement in cystic fibrosis (CF), characterized by the presence of multiple macrocysts partially or completely replacing pancreas. Only few reports are available from literature and management (surgery vs follow up) is commonly based on the presence of symptoms or complications due to local mass effect, although evidence-based recommendations are still not available.
- https://www.ncbi.nlm.nih.gov/pmc/articles/PMC7021641/

Imaging features of IPMN

- Locaiton
- head, uncinate 55%
- body tail 10%
- Diffuse/multifocal 35%
- Ductal abnormalities
- Combined main/side branch duct type 70%
- Isolated side branch duct type 30%
- ductal dilatation 97%
- “masses of mucin”
- Clusters of small cysts from 1-2cm in diameter

Acinar cell carcinoma
- Older men
- Less desmoplastic and often larger than pancreatic adenocarcinoma.
- May be encapsulated
- invades rather than encases vessels
- metastatic fat necrosis
Case Discussion
Ultrasound-guided biopsy of the spleen was performed leading to the rare diagnosis of pancreas acinar cell carcinoma.
Pancreas acinar cell carcinoma highlights:
very rare <1%
exocrine tumour
larger size at diagnosis and often better prognosis than adenocarcinoma
some have paraneoplastic syndrome with hypersecretion of lipase (as in this case), which can lead to fat necrosis of subcutaneous nodules and polyarthralgia
On physical exam, this patient did have subcutaneous nodules in the lower extremities which would be clinically consistent with fat necrosis related to hyperlipasaemia.
which nuclear imaging studies can be useful in looking for insulinomas and why?
Ga-68 DOTATATE PET-CT
About 80% of insulinomas express the somatostatin receptors 2, and the Ga-68 DOTATATE scans have a high affinity for these receptors and, therefore, have high sensitivity in the detection of these tumours, particularly for low-grade and well-differentiated ones 8-10. The sensitivity of this study has been reported in up to 90% 8, when assessing insulinomas specifically, and ranging between 90-100% for pancreatic neuroendocrine tumours as whole 9.
PET-CT is also useful in excluding additional pancreatic neuroendocrine tumours eventually not detected on CT or MRI, particularly, in inherited syndromes such as MEN1 8.
F-18 FDG PET-CT
Neuroendocrine tumours are slow-growing tumours that usually have slow metabolic activity in their initial stages and, therefore, are not notably avid on F-18 FDG PET-CT 9. Tumours with a higher grade or poorly differentiated tend to show marked uptake 8-10.
Acute peripancreatic fluid collections
APFC
- Fluid collections/Phlegmon
- occur in the setting of intersitial edematous pancreatitis
- ie normal pancreatitis
- < 4 weeks after the onset of pancreatitis
- Can either be infected or not
- occur in the setting of intersitial edematous pancreatitis
- Acute peripancreatic fluid collections (APFC) are an early complication of acute pancreatitis that usually develop in the first four weeks. After four weeks, the term pseudocysts is used. The absence of necrosis differentiates APFCs from acute necrotic collections (ANC), that is, APFCs occur in interstitial oedematous pancreatitis, not in necrotising pancreatitis.
- Pathology
APFCs result from pancreatic/peripancreatic inflammation and/or rupture of one of the small pancreatic side ducts 1.

describe a whipples proceedure
- resection of the
- pancreatic head
- duodenum
- gastric antrum
- GB
- a jejunal loop is brought up to the RUQ for gastrojejunal, choledochojenumal or hepatic jejunal and pancreaticojejunal anastomosis
- Some surgeons prefer to perform pancreatoduodectomy to preserve the pylorus when possible
- The pylous preserving pancreatoduodenectomy, the stomach is left intact and the proximal duodenum is used for duodenojejunal anastomosis

What is this?

Ectopic/Heteropic pancreatic tissue
- Present in 1-10% of the population
- Sites
- Stomach (antrum)
- Duodenum
- Smooth submucosal mass often with central umbilication (remnant of PD)
definition of this condition.

Chronic pancreatitis
progressive, irreversible destruction of pancreatic parenchyma by repeated episodes of mild or subclinical pancreatitis
Thick punctate pancreatic calcifications with dilatation of duct of Wirsung. Distended gallbladder. Decreased liver attenuation coefficient, probably due to fat infiltration.
No focal hepatic lesions are observed. Normal adrenal glands and kidneys. No ascites or retroperitoneal lymphadenopathy are observed.
Case Discussion
This case shows typical findings of chronic pancreatitis with calcification and main duct dilatation. This is most commonly associated with chronic alcohol abuse as was the case for this patient.
https://radiopaedia.org/cases/chronic-pancreatitis-5
Imaging features of Groove Pancreatitis/paraduodenal pancreatitis

- CT
- soft tissue in the pancreaticoduodenal groove with delayed enhancement
- small cystic lesions along the medial wall of the duodenum
- MRI
- Sheet like mass in pancreaticoduodenal groove hypointense to pancreas on TI and isointense to slightly hyperintense to pancreas on T2
- delayed enhancement
- cystic lesions in the medial wall of duodenum seen in cystic dystrophy
The walls of the second part of the duodenum are thickened with a small volume of free fluid; there are recognizable ectopic pancreatic islands with a similar degree of enhancement to the rest of the pancreas. The adjacent fat tissue is hyperdense due to inflammation. There are multiple foci of calcification in the pancreas. Normal biliary tree.
Case Discussion
Paraduodenal pancreatitis is characterised by a history of excess alcohol and tobacco use in male patients, and a painful symptomatology. Histology analysis demonstrates granulomatous tissue, stromal proliferation, and ectopic pancreatic tissue within the duodenal wall. The epicentre of the inflammation is typically located between the duodenum, common bile duct and pancreas. The presence of cysts inside the inflamed duodenal wall allows distinguishing between a “cystic” (75%) and a “solid” variant of paraduodenal pancreatitis.
https://radiopaedia.org/cases/paraduodenal-pancreatitis-3















































